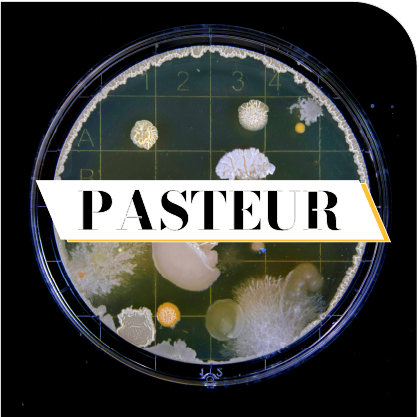
HUVY, la medtech qui révolutionne le diagnostic de peau

Le HIT du mois
Regarder ailleurs est une clé de la curiosité, du partage et de l’inspiration. C’est malin, c’est banger, c’est ici !
Les HITS à ne pas louper
Février
2026
L’IA générative au service de la RSE
Dépasser l’alibi technologique pour agir concrètement
La RSE n’est pas qu’une norme, c’est avant tout une vision
Dans la pratique, beaucoup d’entreprises font de la Responsabilité Sociétale de l’Entreprise (RSE) un étendard sans toujours pouvoir l’ajuster à leurs opérations.
L’intelligence artificielle générative est souvent perçue comme une source d’innovation, plus accessoire que structurante, parce qu’elle est plus simple à tester qu’à intégrer dans une vraie stratégie de transformation.
Pourtant, elle peut devenir un levier pour faire ce que la RSE demande réellement : des résultats mesurables, des processus repensés et une crédibilité accrue auprès des parties prenantes.
Un premier constat provient des enquêtes sur l’adoption de l’IA générative dans les PME françaises : malgré une progression, elle reste encore marginale et cantonnée à des fonctions supports comme la production de contenus ou la recherche d’informations, loin des usages structurants qui pourraient soutenir une démarche RSE ambitieuse.
Seuls 31 % des PME et ETI déclarent utiliser l’IA, la majorité ne sachant pas encore identifier comment l’appliquer à leurs enjeux métiers ou RSE. [Bpifrance Le Lab]
Pain points et dead ends
Les directions de marque et de RSE butent souvent sur les mêmes impasses : une gouvernance RSE trop isolée, des métriques vagues non reliées aux opérations, ou un pilotage des technologies sans lien clair avec les enjeux sociétaux. Sans ce lien, l’IA, même générative, reste un outil gadget plutôt qu’un accélérateur de transformation.
Greenly et le carbon accounting
Cette startup RSE et Climate Tech française a conçu une plateforme SaaS de comptabilité carbone et de pilotage climat, permettant aux organisations de mesurer, suivre et réduire leurs émissions de gaz à effet de serre tout en intégrant ces données dans leurs reportings RSE.
C’est d’ailleurs souvent par-là que commencent les entreprises. Choisir une action qui dégage des KPIs sur lesquels agir et communiquer.
Greenly a une vision produit forte : ils ne se contentent pas de produire un bilan carbone statique : la plateforme connecte automatiquement les données opérationnelles des entreprises (comptabilité, ERP, outils métiers).
C’est aussi une approche démocratisée du carbon accounting. Alors que de nombreux outils concurrents s’appuient encore beaucoup sur des consultants ou des méthodologies manuelles, Greenly a adopté un modèle SaaS tech-first accessible à un large éventail de clients.
Mais l’axe qui a permis une adoption massive c’est la double compatibilité avec les normes même émergentes (CSRD, CBAM, SBTi), et les écosystèmes existants. Devenir un outil central de pilotage a été le pari gagnant.
Quels ROI attendre du recours à un SaaS de carbon accounting ?
- Efficience opérationnelle et réduction des coûts (automatisation des tâches de collecte de données, de calculs et de reportings).
- Fiabilité et conformité réglementaire : données « audit-ready », conformes aux normes et acceptées par les parties prenantes externes.
- Amélioration de l’attractivité financière et commerciale : une démarche RSE structurée rassurent les investisseurs, attire les talents et convainc les consommateurs.
- Impact stratégique sur les objectifs RSE : au-delà des économies directes, les plateformes facilitent l’identification d’axes de réduction d’émissions et de plans d’action mesurables.
L’objectif est bel et bien de transformer la RSE d’un exercice déclaratif en un levier d’innovation et d’avantage compétitif.
La RSE devient une plateforme industrielle et technologique
À l’autre extrémité de l’échelle, regarder comment un géant industriel structure sa stratégie et donne des repères. Schneider Electric, parmi les leaders mondiaux en matière de performance durable et d’intégration de l’efficacité énergétique, illustre l’ambition de lier innovation technologique et engagements RSE dans une feuille de route cohérente : optimiser l’efficience énergétique globale, intégrer des solutions numériques pour réduire l’impact de ses produits et s’engager sur des objectifs bas carbone vérifiables.
Chez Schneider Electric, l’ambition est de faire de l’IA elle-même un moteur de durabilité intégré aux opérations, pas seulement un outil de reporting. C’est une démarche de « durabilité augmentée » par IA où la technologie est imbriquée dans les processus et la gouvernance interne.
Une vision avant l’action :
adopter une architecture d’usage
Pour une PME qui veut aller au-delà du test ou de la répétition de prompts, la démarche gagnante n’est pas d’abord technologique mais stratégique. Il s’agit de :
- Choisir des enjeux RSE clairement quantifiables. Par exemple, une cible de réduction de GES ou de performance énergétique.
- Relier ces enjeux à des cas d’usage IA générative précis : optimiser les scénarios d’achats responsables, générer des tableaux de bord ESG automatisés, créer des synthèses de données complexes pour les dirigeants.
- Mesurer les résultats avec des KPIs actionnables et les intégrer dans les dispositifs de reporting internes et externes.
Ce n’est pas magique. Cela s’apparente plutôt à une architecture d’usage : on part d’un objectif RSE, on identifie la donnée utile, on crée un flux de valeur assisté par IA, et on boucle avec une mesure et un ajustement continu.
Une PME peut conduire cette transformation en interne si elle combine quatre leviers : une gouvernance multi-disciplinaire (opérations, RSE, data), une feuille de route claire avec des jalons précis, des outils simples à intégrer dans les processus existants, et une acculturation des équipes. Ce chemin demande de la structure plus que de la sophistication, et c’est précisément là que le rôle des brand strategist, qui organisent sens, action et impact, se révèle décisif.
Janvier
2026
Institut Pasteur
Et si la révolution médicale de demain venait… de vos bactéries ?
Il y a des révolutions qui font du bruit.
Et celles qui travaillent en silence.
La recherche choisit d’explorer le vivant
À l’Institut Pasteur, les chercheurs ne sont pas en quête d’une nouvelle molécule miracle. Ils explorent un écosystème déjà bien installé en vous : le microbiome intestinal.
Leur constat est désormais étayé par la recherche clinique : ce monde invisible joue un rôle central dans la construction de notre immunité, en particulier dès l’enfance. Une piste documentée par des publications dans Gut et Frontiers in Microbiology, qui pourrait bien réinventer la prévention médicale.
La recherche française qui fait avancer la médecine
Plusieurs avancées majeures ont été mises en évidence sous l’impulsion de Benoît Chassaing, directeur de recherche Inserm et responsable de l’équipe Interactions Microbiote–Hôte à l’Institut Pasteur.
Les perturbations précoces du microbiome, liées notamment à l’usage d’antibiotiques, à l’alimentation ou à l’environnement, sont associées à une augmentation du risque d’eczéma, d’asthme et d’allergies chez l’enfant.
Le microbiome apparaît comme un biomarqueur prédictif : l’analyse de sa composition permet d’anticiper certaines réponses immunitaires individuelles.
La modulation ciblée du microbiome ouvre la voie à une médecine préventive, personnalisée et moins invasive.
Le point décisif, c’est que ces travaux ne relèvent plus de la théorie. Ils sont portés par des institutions scientifiques de premier plan comme l’Institut Pasteur et l’Inserm, et soutenus par des programmes de recherche européens, notamment Horizon Europe.
La recherche fondamentale bascule progressivement vers des applications cliniques concrètes.
Pourquoi c’est une très bonne nouvelle pour 2026
D’abord parce que l’on change de logique. Prévenir plutôt que guérir. En agissant sur le microbiome dès la petite enfance, il devient possible de réduire l’incidence de maladies chroniques telles que les allergies, le diabète ou certains troubles métaboliques. On n’attend plus que le système immunitaire se dérègle : on cherche à l’accompagner dès le départ.
Ensuite parce que cette approche ouvre la voie à une médecine plus douce et plus soutenable. Moins d’antibiotiques, moins de traitements lourds, davantage de solutions ciblées reposant sur la nutrition, les prébiotiques ou les probiotiques. Plusieurs études publiées dans The Lancet soulignent d’ailleurs le potentiel de réduction des coûts pour les systèmes de santé à moyen terme.
Enfin parce que les applications dépassent largement le cadre hospitalier. Santé préventive, nutrition, dermo-cosmétique, bien-être : le microbiome devient un nouveau socle d’innovation, avec un impact direct sur la manière dont les marques conçoivent leurs produits et leurs promesses.
Ce que cela change pour vous
Si vous êtes parent, des outils de dépistage de plus en plus simples pourraient bientôt vous aider à adapter l’alimentation de votre enfant pour soutenir son immunité dès les premières années.
Si vous êtes entrepreneur, le microbiome n’est plus un sujet de niche. Il structure déjà des marchés entiers, de la biotech à l’agroalimentaire, avec des opportunités B2B et B2C encore largement ouvertes.
Si vous êtes communicant ou marketeur, le microbiome offre un terrain narratif puissant : invisible, scientifique, universel et profondément humain. Une matière idéale pour des campagnes éducatives à fort impact.
Ce que révèle cette avancée, ce n’est pas seulement une innovation scientifique. C’est un changement de regard. La santé ne se résume plus à combattre des symptômes, mais à comprendre et préserver des équilibres.
Ce qui me frappe dans cette révolution, c’est son caractère systémique et accessible. On ne parle pas d’un traitement hors de portée, mais de solutions préventives, fondées sur la connaissance, et alignées avec une vision plus globale de la santé. C’est exactement le type d’innovation capable de transformer durablement les marques, les usages et la relation au soin.
2025
Blast
Quand une marque d’investissement devient un phénomène culturel
Il y a des marques qui vendent un produit.
Et il y a celle qui vendent un mythe.
C’est quoi le Blast Club ?
Blast Club, fondé en 2023 par Anthony Bourbon [Vu à la TV : M6, Qui veut être mon associé] et Samuel Guez [My Jolie Candle], est un club d’investissement privé.
Soyons honnête : l’investissement start-up, dans l’imaginaire collectif, c’était jusque-là un club très fermé, assez gris, réservé à ceux qui disent “deal-flow” avant leur café.
Mais ces deux là ont retourné le script.
Blast Club ouvre aux particuliers l’accès à des deals de start-ups à fort potentiel, souvent réservés aux pros ou aux gros fonds.
L’idée ? Permettre à chacun d’investir dès 1 000 € dans des start-ups européennes (mais aussi des pépites accélérées par le mythique Y Combinator) : deep-tech, IA, medtech, spacetech, fintech… bref, l’innovation à haut risque, mais potentiellement ausi à gros rendement.
Le concept va plus loin qu’un simple crowdfunding :
Accès privilégié : une vingtaine de levées par an, avec due diligence, sélection de projets, accès en amont des promotions Y Combinator et deals exclusifs.
Flexibilité de ticket : dès 1 000 €, et des paliers variés selon le niveau d’adhésion, ça permet à des profils divers d’y entrer et pas seulement les gros portefeuilles.
Accompagnement & communauté : formation en ligne, accès à un réseau de 10-15 000 membres, événements, canaux d’échange, pitchs live avec les fondateurs des start-ups et l’équipe Blast : un environnement “startup + investisseurs” ouvert.
Transparence & simplicité : l’administratif, la structuration et le juridique sont gérés par Blast, pour que l’entrée dans le capital-risque soit (relativement) fluide pour un particulier.
Un storytelling messianique, calibré pour créer une tribu
Anthony Bourbon n’a pas seulement fondé un club : il a posé un héros au centre de l’histoire. Son parcours, dur, méritocratique, volontaire, sert de preuve sociale vivante. Le personal branding qui vaut un 10.
Ce qu’il raconte au public, c’est :
« Si je l’ai fait, vous pouvez le faire aussi. »
Du mécénat mental, presque.
Cette narration donne aux membres l’impression d’être dans l’histoire, pas juste clients du produit.
Une mécanique redoutablement efficace pour fédérer.
Le branding de l’accès :
“tu n’es pas riche…
mais tu deviens insider”
Le coup de génie de Blast ? Avoir transformé une contrainte (ticket d’entrée élevé chez les fonds traditionnels) en promesse identitaire. Ils ont placé le discours là où ça pique : « Vous êtes tenus à l’écart ? Pas chez nous. »
Résultat : Blast Club ne vend pas seulement des deals.
Ils vendent un courant d’air frais dans un monde verrouillé.
L’impression que quelqu’un a ouvert une porte secrète, et qu’on vous fait signe d’entrer.
Une esthétique forte : sombre, nette, ambitieuse, premium sans posture
Blast ne joue pas la carte du luxe à l’ancienne. Leur identité navigue dans un registre beaucoup plus contemporain : sobriété tech, contrastes assumés, lignes propres, codes “premium” sans l’arrogance.
Le noir profond, les aplats épurés, la typographie précise, les visuels quasi-futuristes…
Tout concourt à donner l’impression d’un produit haut de gamme, mais pensé pour ceux qui aiment la performance plutôt que le décorum.
On n’est ni dans la banque traditionnelle, ni dans la startup fluo.
On est dans une zone hybride, quelque part entre un dashboard SpaceX, un fond VC de nouvelle génération et un club privé ouvert aux audacieux.
Ce n’est pas seulement une plateforme d’investissement.
C’est une architecture de confiance. Un système. Un état d’esprit d’investisseur moderne.
Le contenu comme accélérateur de désir : un marketing éducatif… qui flatte l’ego
Le club nourrit sa communauté avec un mix subtil :
-
contenu pédagogique (pour rassurer)
-
contenus sur les deals (pour exciter)
-
contenus sur l’équipe (pour incarner)
-
contenus sur la communauté (pour rallier)
Chaque communication est un mini-rituel :
“Regardez ce que vous pouvez comprendre, regarder, décider… parce que vous êtes désormais de l’autre côté.”
Là encore, du branding pur.
On ne vous parle pas à vous, on parle avec vous.
Vous êtes déjà dans la pièce.
La rareté savamment mise en scène
Le “deal limité”, “deal sursouscrit”, “dernières heures”…
Ce n’est pas nouveau.
Mais Blast l’utilise comme un levier communautaire, pas seulement commercial.
La rareté ne dit pas : « Dépêche-toi. » Elle dit : « Ceux qui comprennent, comprennent vite. » Et personne n’a envie d’être dans le mauvais camp.
Le community building comme produit
Blast n’est pas un club :
c’est une salle de sport pour flexer son intelligence financière.
Les membres y viennent pour :
-
dire qu’ils en font partie
-
apprendre derrière le rideau
-
se montrer dans un environnement valorisant
-
s’identifier à un univers d’innovation et de réussite
Ce qui est fascinant, c’est qu’au fil du temps, la communauté devient l’argument de vente.
Une boucle infinie digne d’une masterclass de Seth Godin.
Blast a capté l’aspiration culturelle du moment
On vit une époque où les gens veulent reprendre le contrôle de leur argent, comprendre ce dans quoi ils investissent, et être connectés au futur plutôt qu’à un livret A.
Blast arrive avec un discours parfaitement dans l’air du temps :
“Vous voulez participer au futur ? Rentrez dans l’arène.”
Ils n’ont pas seulement vendu l’accès à l’investissement.
Ils ont vendu le pouvoir d’agir.
Et ça, c’est du branding très, très bien pensé.
Blast n’est pas une success story financière
C’est une success story culturelle.
La marque a réussi à :
-
rendre l’investissement émotionnel
-
transformer un club privé en mouvement
-
faire de l’aspiration sociale un produit
-
créer un imaginaire qui vaut autant que les deals
Le futur des marques d’investissement ressemble beaucoup plus à Blast… qu’à une banque en costume gris.
Révisez vos connaissances sur la culture de marque, inspirez-vous et auto-évaluez la vôtre.
2025
Huvy
Que fait Huvy ?
HUVY, lancée en 2021, s’est imposée comme la medtech qui transforme… une simple photo de peau en un diagnostic rapide et accessible.
Grâce à l’intelligence artificielle, autrement dit un algorithme capable d’analyser en quelques secondes une lésion pigmentée, HUVY permet d’évaluer le risque de mélanome sans attendre un rendez-vous médical. Ce concept simple mais puissant a séduit : après un démarrage prometteur, la startup a rapidement élargi ses solutions et son audience, et continue de séduire patients et professionnels de santé.
En clair : HUVY part d’un besoin critique (dépister tôt pour sauver des vies) pour en faire une promesse concrète, utile, rassurante, et surtout profondément humaine.
Mais l’atout le plus fort de HUVY ne réside pas seulement dans l’efficacité clinique, c’est dans la manière dont elle met en lumière une réalité parfois ignorée : derrière chaque “cas suspect”, il y a un être humain, un patient, une vie potentiellement bouleversée.
Leur com’ joue sur l’émotion,
et ça change tout
Donner un visage au risque : HUVY ne communique pas en jargon technique. Elle parle d’atteintes à la peau, de cancers cutanés, de vies sauvées. En soulignant qu’une détection précoce multiplie les chances de guérison, elle transforme une démarche médicale en enjeu profondément humain.
Urgence + espoir : Dans un contexte de pénurie de dermatologues et de délais interminables pour un rendez-vous, HUVY propose un pont entre l’angoisse du “et si c’est grave” et le soulagement d’un tri rapide.
Accessibilité & empowerment : En rendant le dépistage plus accessible, via un simple cliché analysé par IA, HUVY réhumanise l’accès aux soins : c’est moins “spécialiste inaccessible” qu’“outil de prévention accessible”. Ce discours rassure, engage, rend concret l’impact.
Vision vertueuse et engagée : HUVY ne vend pas un simple produit. Elle vend une mission : désengorger le système, prioriser les urgences, sauver des vies. Une mission qui parle à la fois aux professionnels de santé, aux patients, mais aussi à ceux, comme nous, qui croient en la puissance de la com’ utile.
Ce que j‘en pense, et ce que ça dit de la com’ BtoB de demain
HUVY prouve que la com’ BtoB, même en medtech, n’a pas à rester figée dans le fonctionnel. Elle peut, et doit, raconter des histoires. Elle peut donner du sens. Elle peut toucher l’émotion.
Quand la technique sert l’humain, et qu’on ne l’oublie pas dans la narration, c’est là que la marque change de statut : de “fournisseur de solutions” à “acteur de transformation”, capable de fédérer autour d’une mission.
Et pour vous, communicants en quête d’impact, c’est un modèle : une com’ engagée, qui parle le langage des valeurs, des vies, des urgences, pas seulement celui des fonctionnalités.
Découvrez d’autres marques innovantes qui même en B2B font sensation avec de l’émotion.
2025
Voshbon
Le soin minimaliste rime avec maximal impact (et plaisir mousseux)
Qui est Voshbon ?
J’ai découvert Voshbon sur le salon Cosmetic 360. Voshbon, c’est la marque qui réinvente le geste le plus banal de notre routine beauté, se laver, en le transformant en rituel à la fois intelligent, efficace et engagé. Grâce à une technologie radicale de lyophilisation (“freeze-dried / waterless”), Voshbon propose des nettoyants visage, corps et cheveux sans eau dans le flacon. Il s’agit de formules ultra-concentrées sous forme de granules, activées simplement avec un peu d’eau pour redevenir une mousse luxueuse et performante.
Autrement dit : là où la majorité des shampoings ou gels douche contiennent 80-90 % d’eau, Voshbon choisit de l’ôter complètement, pour remettre l’actif au cœur du geste.
Résultat ? Un soin plus concentré, plus respectueux de la peau et… beaucoup plus sobre en ressources.
Pourquoi c’est (pour le moment)
l’un des concepts les plus malins
de la Beauty-tech
Efficacité + minimalisme : Voshbon ne dilue pas les actifs. Probiotiques, huiles végétales, vitamines, agents microbiome-friendly : tout reste à pleine puissance jusqu’au moment où tu réactives avec de l’eau. Gain de performance, mais aussi de sens.
Éthique & écoresponsable assumée : chaque flacon Voshbon de 75 g, soit l’équivalent d’environ 750 mL de produit liquide classique, permet d’économiser 3,5 litres d’eau, tout en réduisant jusqu’à 80 % des émissions CO₂ liées au transport.
Format compact & nomade : idéal pour ceux qui voyagent, déménagent souvent, ou veulent réduire le volume de leurs produits, un plus non négligeable dans une époque où l’on cherche tous à rationaliser, purifier, simplifier.
Un nouveau récit de beauté : Voshbon ne vend pas un simple soin, elle propose une philosophie : “beauté qui ne coûte pas la planète, soins concentrés, peau saine, impact réduit”. Une posture qui parle à une génération consciente et exigeante.
Ce que ce positionnement dit,
et ce qu’il peut ouvrir
Voshbon incarne la symbiose parfaite entre science, écologie et routine intime. Elle répond à un besoin concret (nettoyer) tout en questionnant nos habitudes, nos réflexes, nos priorités. Dans un marché saturé de “beauté liquide”, elle ose le sec, le concentré, le minimal, une sorte de “slow beauty version 2.0”.
Avec ce type d’approche, la marque ne s’adresse plus seulement aux puristes du green ou aux early adopters : elle peut toucher un public large, sensible aux enjeux climatiques, à l’efficacité, mais aussi au design et à l’expérience quotidienne. Autrement dit, Voshbon a le profil d’une marque qui peut devenir… mainstream, sans hypocrisie, et garder son âme d’outsider.
Pourquoi ça me plaît
J’adore à quel point Voshbon fait rimer “nettoyage / soin” avec “conscience & modernité”. Chaque douche ou lavage devient un petit geste militant, non pas militant “gentil greenwashing”, mais militant pour l’intelligence, l’efficacité, le respect : de notre peau, de notre corps, de la planète.
C’est le genre de marque qui incarne ce que j’aime dans la com’ contemporaine : directe, honnête, utile, et capable de raconter une histoire qui a du sens. Bref, je garde un œil attentif sur leur trajectoire.
Si vous voulez creuser mes insights après ma visite du salon Cosmetic 360 ou réviser les innovations relevées par les premiers Grands Prix Stratégies de la Beauté.
2025
Hyland
Hyland transforme la data en poésie (et signe l’un des bangers de com’ BtoB de l’année)
Que vend Hyland ?
Hyland, c’est l’entreprise qui transforme le quotidien le plus invisible des organisations : la gestion des documents et des processus. Avec sa plateforme OnBase et son Content Innovation Cloud, Hyland ne vend pas juste des logiciels : elle vend de l’efficacité, de la fluidité, et la capacité à transformer des montagnes de données en décisions intelligentes. Autrement dit, là où beaucoup ne voient que des PDF et des formulaires, Hyland voit de la valeur, du rythme, et des opportunités.
Et la tech B2B rencontre l’émotion
Et puis Hyland a fait quelque chose de surprenant : elle a associé cette puissance “back‑office” à de l’émotion pure.
Avec le clip “The Flight of the Valtteri”, l’entreprise a mis en scène le pilote Valtteri Bottas, ses données biométriques, ses performances et son adrénaline… pour créer une expérience sensorielle et musicale.
D’un coup, l’invisible devient palpable : la donnée et la tech racontent une histoire, donnent du frisson, et transforment le B2B en storytelling immersif.
La campagne en détail
Le projet n’est pas un simple film promotionnel. Hyland a :
- capté les données biométriques du pilote en direct,
transformé ces chiffres (rythme cardiaque, respiration, accélérations) en éléments musicaux,
produit un clip magistral où chaque accélération de Valtteri se traduit en son et en rythme, reliant performance et sensation.
Le résultat : un mix subtil entre tech, innovation et émotion, où Hyland ne se contente plus de vendre un produit : elle raconte une histoire vivante et palpable, qui touche autant les amateurs de tech que les passionnés d’expérience sensorielle.
Pourquoi c’est inspirant
Cette campagne illustre plusieurs leçons :
- Rendre visible l’invisible : derrière chaque processus, chaque document, il y a une énergie, un rythme, un potentiel. Hyland le matérialise par la musique et le récit.
- Transformer un secteur perçu comme aride : l’ECM et la gestion documentaire deviennent des terrains d’inspiration, de storytelling et de fierté.
- Aligner technique et émotion : la puissance de la plateforme rencontre l’expérience humaine, la data rencontre le frisson, et la tech B2B devient désirée, admirée, partagée.
Hyland prouve ainsi qu’on peut allier rigueur et créativité, structure et émotion, productivité et sens. Dans un monde où les données explosent, où la transformation digitale est clé, ce type de campagne montre que la tech B2B peut aussi faire rêver.
Découvrez le clip The flight of the Valtteri et musclez votre storytelling B2B avec notre Partage. [Bientôt disponible sur la page MOBILISATION]
2025
Air Up & Kaizen
Qui est Air Up ?
Air Up, lancée en 2018, s’est imposée comme la startup qui transforme… l’eau en expérience.
Grâce à la rétro-olfaction, autrement dit l’arôme “virtuel” délivré par des pods odorants, la gourde d’air up donne l’illusion d’eau aromatisée, sans sucre, sans additif. Ce concept simple mais malin a séduit : après un démarrage fulgurant (80 000 gourdes vendues en 6 semines, la marque a étendu ses marchés et multiplié ses références, jusqu’à compter aujourd’hui des revenus à plusieurs centaines de millions d’euros.
En clair : air up part d’un besoin banal (s’hydrater) pour en faire une promesse lifestyle, fun, saine, design et… “instagrammable”.
Air Up + Inoxtag
un move stratégique brillant
Quand Inoxtag annonce en 2023 qu’il part s’attaquer à l’Everest, air up entre dans le storytelling. L’entreprise ne se contente plus de vendre une gourde, elle s’inscrit dans un récit de dépassement de soi, d’aventure, de mode de vie. Pour la sortie de Kaizen, air up & Inoxtag ont co-créé une édition limitée de gourde “Everest” — code couleur, motifs montagne, ambiance expé designée par le talentueux Louis Roy aka Thurb.
En s’associant à un défi extrême (montagne, effort, risque, transformation personnelle), la marque s’ancre dans un imaginaire fort, celui de la performance, de l’endurance, du goût de l’effort. Un terrain d’émotion bien plus puissant qu’un simple affichage produit.
Les chiffres parlent et donnent le vertige
Kaizen, dès sa mise en ligne sur YouTube, a généré 11,6 millions de vues en 24 h, record national. Aujourd’hui, le documentaire cumule 44 millions de vues sur la plateforme.
Côté influence, Inoxtag a gagné +300 000 abonnés après la sortie du film. Plus de 220 000 nouveaux followers sur Instagram également.
Pour air up : le partenariat s’inscrit dans une stratégie plus globale, pas de pub TV, quasiment que du “creator/influence marketing”, ce qui a permis à la marque d’exploser tout en construisant une image forte.
Bref, ce n’est pas qu’une co-édition de gourde. C’est un levier d’image, de croissance, de storytelling.
Pourquoi ça fonctionne
Transformation de produit banal > émotion & identité : air up illumine l’ordinaire (boire de l’eau) en le rendant désirable, ludique, valorisé. Ajouter l’élément aventure et la marque gagne un supplément d’âme.
Culture de l’engagement & de la communauté : en misant sur l’influence, le partage d’un récit, le lifestyle plutôt que la vente agressive, air up construit une relation de confiance et d’adhésion — ce qui paie sur le long terme.
Alignement valeurs – produit – récit – client : eau saine, envie de bien-être, goût de l’effort, envie de défis : tout est cohérent, ce qui rend le message crédible et authentique.
Scale up par l’image : la visibilité d’un projet comme Kaizen dépasse largement le cadre d’une campagne classique ; c’est un storytelling global, multiplateforme, qui génère des retombées massives.
Ce que j’en pense, et les (bons) signaux pour l’avenir
À mes yeux, air up illustre une tendance de fond : les marques, même dans des secteurs “banals” ou utilitaires, ont tout intérêt à investir dans le sens, l’émotion, le récit. Ce que vend air up, ce n’est pas qu’une gourde : c’est un style de vie. Ce que vend Kaizen ce n’est pas qu’un documentaire : c’est un rêve, un effort, un symbole de ce qu’on peut faire quand on ose viser haut.
Si vous êtes passionnés par les marques qui construisent du sens… ça vaut le coup de suivre leurs prochains mouvements. Parce qu’ils ne misent pas sur le buzz ponctuel, mais sur la construction d’un univers.
Découvrez d’autres histoires de marques qui parlent à la génération Alpha dans notre série bientôt disponible sur Youtube.